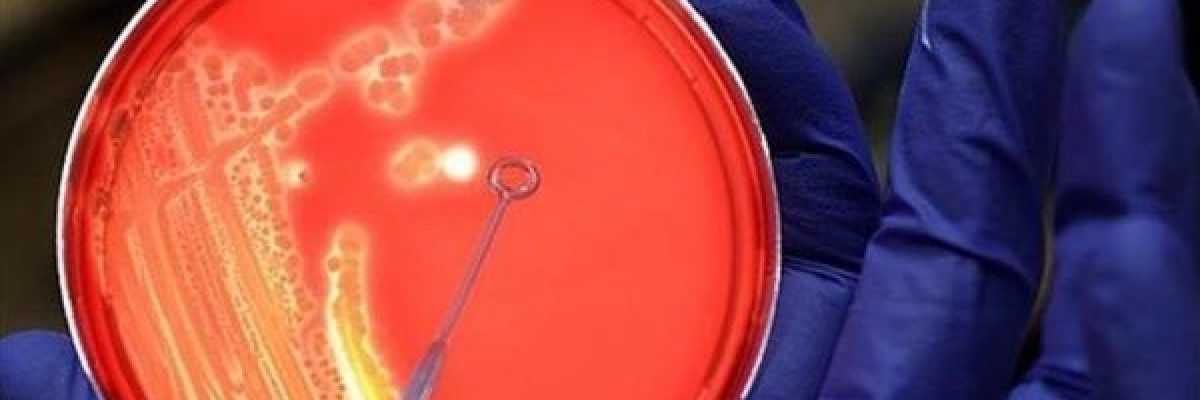
اكتشاف-بكتيريا-قد-تساعد-البشر-على-استعمار-كوكب-المريخ

اخبار اليوم الصحيفة, اكتشاف بكتيريا قد اخبار اليوم الصحيفة, اكتشاف بكتيريا قد
كشفت دراسة استرالية حديثة، ان نوعًا غريبًا من البكتيريا، يمكنه تحويل الضوء الى وقود واكسجين، في بيئات قاتمة بشكل لا يصدق، ما يساعد البشر على استعمار كوكب المريخ.
الدراسة اجراها باحثون بالجامعة الوطنية الاسترالية، ونشروا نتائجها في العدد الاخير من دورية (Science) العلمية.
واوضح الباحثون ان “هذه البكتيريا يمكن ان تساعد البشر يومًا ما في استعمار كوكب المريخ، وتوسيع نطاق البحث عن الحياة على كواكب اخرى”.
واضافوا بان “هذه البكتيريا تسمى البكتيريا الزرقاء، وهي تمتص اشعة الشمس لخلق الطاقة، وهي شعبة من البكتيريا قادرة على التمثيل الضوئي، وعادة ما تعيش في الماء”.
وتحوي البكتيريا الزرقاء على 3 صبغات، الاخضر والازرق والاحمر، والصبغة الخضراء هي “الكلوروفيل” وتساعدها في عملية التمثيل الضوئي، اما الصبغة الزرقاء فهي التي تعطيها اللون الازرق، والسبب في ذلك يرجع الى كثرة وجود الصبغة الزرقاء داخلها.
اما الصبغة الحمراء فهي “بيتا كاروتين”، ويستدل على وجودها من طائر “الفلامنجو”، فعندما يشرب الفلامنجو الماء، تدخل البكتيريا الزرقاء لجسمه، فيظهر اللون الوردي على بعض اجزاء جسمه.
ويعتقد الباحثون ان “هذه البكتيريا يمكن ان تمتص فقط اطوال موجية محددة من الضوء، لكن الدراسة الجديدة اكتشفت ان نوعًا واحدًا على الاقل من البكتيريا الزرقاء، يسمى (Chroococcidiopsis thermalis)، يعيش في بعض اكثر البيئات تطرفًا في العالم، يمكنه استيعاب الاطوال الموجية الشديدة الاقل نشاطًا للضوء، ما يسمح له بالازدهار في الظروف المظلمة، مثل الاعماق تحت الماء في الينابيع الساخنة”.
وقالت “جينيفر مورتون”، احدي المشاركات في البحث العلمي، ان “هذا العمل يعيد تحديد الحد الادنى من الطاقة المطلوبة في الضوء للتمثيل الضوئي”.
واضافت “قد يحدث هذا النوع من التمثيل الضوئي في حديقتك، او تحت صخرة، لانه تم العثور على نوع يشبه هذه البكتيريا ويعيش داخل الصخور في الصحراء”.
واشارت الى انه “من خلال دراسة الالية الفيزيائية لقدرات امتصاص هذه الكائنات الحية، يتطلع الباحثون لمعرفة المزيد عن كيفية عمل التمثيل الضوئي، ما يزيد من امكانية استخدام كائنات مماثلة لتوليد الاكسجين في اماكن مثل المريخ”.
وقال الدكتور “الماس كراوسز”، احد المشاركين في البحث، ان “هذا قد يبدو مثل الخيال العلمي، ولكن وكالات الفضاء والشركات الخاصة حول العالم، تحاول جاهدة لتحويل هذا الموضوع الى حقيقة في المستقبل القريب”.
واضاف انه “يمكن من الناحية النظرية تسخير التمثيل الضوئي مع هذه الانواع من الكائنات الحية، لتوفير هواء للبشر للتنفس على المريخ”.
واضاف كراوسز “يمكن ان تنمو الكائنات الحية مثل البكتيريا الزرقاء التي ندرسها، تحت الصخور، ويمكن ان تنجو من الظروف القاسية على الكوكب الاحمر”.
وتخطط “ناسا” على المدى الطويل، الى انزال رواد فضاء على سطح المريخ في منتصف ثلاثينات القرن الجاري.
ومنذ عام 2004 ارسلت “ناسا” مركبات فضاء غير ماهولة؛ ابرزها المسباران “كوريوسيتي” و”ابورتسونيتي”، الى كوكب المريخ، وارسلت المركبات صورًا عديدة الى الارض، وتواصل اجراء ابحاث على سطح الكوكب الاحمر.
ويهدف مشروع “مارس ون” الذي ترعاه “ناسا”، الى ارسال مجموعة من الاشخاص في رحلة ذهاب بلا عودة الى سطح المريخ للعيش عليه، مع العمل في نفس الوقت على تصويرها وتسويقها كعرض تلفزيوني، وبالفعل تطوع 200 الف شخص تقريبا من 140 دولة حتى الان للقيام بالرحلة.
الاناضولاكتشاف بكتيريا قد تساعد البشر على استعمار كوكب المريخ